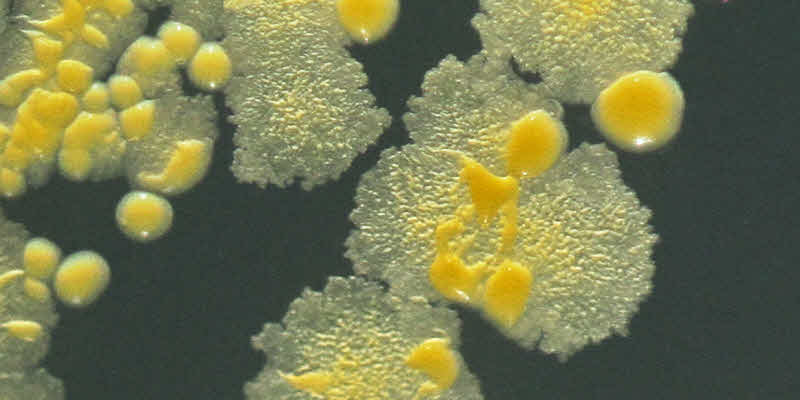

Los incumplimientos en la agricultura cubana durante el 2024, que tanto impactaron en la alimentación de la población y en los altos precios, conllevaron a que una de las prioridades del Plan de la Economía del 2025 sea lograr incrementos en los principales renglones agropecuarios.
Cuba

Una compañía dominicana exportó casi un millón de huevos a Cuba en una semana
Por falta de piensos, la producción nacional bajó de 5 millones de unidades al día en 2020 a 2,2 en 2023.
La fábrica de leche en polvo de Camagüey apuesta por mejores rendimientos
Con una tecnología de avanzada y la búsqueda constante de alternativas en condiciones muy difíciles para el país, la fábrica de leche en polvo de Camagüey apuesta por mejores rendimientos de cara al segundo semestre del año.
Inauguran en La Habana la Feria Internacional de Alimentos Cuba 2024
Con el objetivo de promover la inversión extranjera, aumentar las capacidades productivas y generar alianzas que fortalezcan la industria nacional, fue inaugurada este martes en Pabexpo la Cuarta Feria Internacional de Alimentos, Bebidas, Envases y Tecnología Alimentaria (Alimentos Cuba 2024).
Industria Láctea afectada por el decrecimiento en la entrega de leche
El análisis a las limitaciones económicas y materiales que afectan el incremento de las producciones, lo que repercute en la alimentación del pueblo centró el debate en la asamblea de balance de la Empresa de productos lácteos Granlac, de Granma.
Empresa cárnica elabora embutidos con harina de arroz y maicena en Cienfuegos
La empresa cárnica estatal de Cienfuegos elabora embutidos con harinas de arroz y yuca, además de maicena, según reporte de la prensa local.
Cuba permite la importación de carnes frescas envasadas
La crisis económica que enfrenta Cuba, donde cada vez es más difícil conseguir alimentos, ha obligado a las autoridades cubanas a enmendar una disposición divulgada en agosto sobre la importación de alimentos para permitir la importación de carne fresca, congelada, deshidratada o semielaborada, como hamburguesas y picadillo.
Mercado de manzanas y peras Argentinas en Cuba
Una comitiva argentina participó del evento realizado en Cuba. Asistió el secretario Murchison, quien mantuvo conversaciones tendientes a abrir ese mercado para las manzanas y peras de nuestro país. El secretario de Alimentos y Bioeconomía de la Secretaría de Gobierno de Agroindustria, Andrés Murchison, encabezó la delegación empresarial argentina que participó en la Feria Internacional de la Habana -FIHAV 2018-, entre el 29 de octubre y el 1 de noviembre.
Microorganismos benéficos y naturales para la calidad de los alimentos
El Ingeniero Agrícola Doctor Teuro Higa, profesor de Horticultura de la Universidad de Ryukyus en Okinawa, Japón creó una tecnología en la década de los ochenta relacionada con el uso de los microorganismos eficientes. Los Microorganismos Eficientes, como inoculante microbiano, restablecen el equilibrio microbiológico del suelo, mejoran sus condiciones físico-químicas, incrementan la producción de los cultivos y su protección,
Evaluación energética del proceso de elaboración de helado
La fabricación de helado es una de las producciones más consumidoras de energía dentro de la industria alimentaria cubana, por lo general estos centros cuentan con una planta de refrigeración que proporciona los requerimientos para las etapas de enfriamiento en el proceso productivo.
Leche fermentada de cabra con cultivos probióticos
En los últimos años, la leche de cabra ha sido objeto de diversos estudios, los mismos han demostrado una serie de ventajas con respecto a la leche de otras especies. Es una fuente excelente de proteínas y provee un gran número de aminoácidos esenciales. Es además rica en calcio y muchas vitaminas (A, D, B1, B2, B12).
La clave para obtener la talla comercial correcta en el azúcar
Desde el comienzo de la industrialización, el hombre ha buscado las formas y procedimientos para que los trabajos se realizaran de forma más ágil y que resulten menos tediosos para el propio operador. El siglo XX marcó el inicio de una etapa en el desarrollo científico técnico sin precedentes hasta el momento. En él se han logrado cambios importantes en lo referente a tecnología de los procesos productivos y teoría de los sistemas de control de la Industria.
La capacidad de propagación de los microorganismos probióticos
En la actualidad, el interés por los alimentos probióticos se ha incrementado, sobre todo al comprobarse sus beneficios en la salud de los consumidores. Los microorganismos que se emplean con más frecuencia en la elaboración de estos productos son: Lactobacillus acidophilus, Bifidobacterium bifidum y Lactobacillus casei.
Inoculante con alto impacto en la siembra mecanizada de soja
El documento publicado por Centro de Ingeniería Genética y Biotecnología en la Habana, describe un procedimiento para la producción masiva de radyrhizobium japonicum en un agitador orbital multi-plataforma y el uso del cultivo bacteriano para la inoculación de semillas de soja. Fijación simbiótica de nitrógeno es crítico para la soja ( Glycine max L. Merrill ) se obtiene con la protección al medio ambiente. La cepa B. japonicum fue seleccionada en base a su eficiente interacción simbiótica con las principales variedades de soja cosechados en Cuba.
Cápsulas duras de Tamarindus indica L
Desde la antiguedad, las especies vegetales han sido utilizadas con fines terapéuticos, para el tratamiento de diferentes enfermedades. En la actualidad, hay un retorno mundial a la utilización de los productos naturales, en especial de las plantas medicinales. Cuba cuenta con una variada y abundante flora medicinal. Dentro de esta, se encuentra el Tamarindus indica L. (Caesalpinaceae) o tamarindo como comúnmente se conoce. Esta es la planta medicinal más utilizada por la población, para el tratamiento de las enfermedades hepáticas.
La genética en Cuba trabaja en la búsqueda de plantas más productivas y adaptadas
El paradigma que dominaba las relaciones suelo-planta se concentraba en los procesos exógenos del suelo y ponía menos atención en los procesos endógenos, que deben ser mejor conocidos y utilizados. Durante las últimas dos décadas, un nuevo paradigma para la producción vegetal ha evolucionado e involucra el rendimiento de los cultivos con la integración de los recursos, los factores productivos y las interacciones entre los procesos que manejan el sistema suelo-planta.
Análisis de peligros y puntos críticos de control en una planta de helados
Los clientes son cada vez más exigentes en cuanto a las condiciones de los productos que disfrutan, van a la búsqueda de aquellos que satisfagan sus expectativas, que ofrezcan confianza y seguridad. En el caso de los productos de la cadena de alimentos, una de las cuestiones que más impactan en los mismos es lo relacionado con la inocuidad de los alimentos, si se tiene en cuenta que al definir de un alimento inocuo se propone la entrega de un producto sin riesgo biológico, físico o químico alguno.
Hidrología Isotópica para el monitoreo de contaminantes en el agua
El 14o Simposio Internacional sobre Hidrología Isotópica que se realizó del 11 al 15 de Mayo del corriente año, reunió a más de 400 profesionales que exploraron los temas del agua y el clima, la situación actual de la hidrología isotópica y cómo las técnicas isotópicas pueden ser ampliamente aplicadas.
Efecto de la inoculación con bacterias rizosféricas y Trichoderma en trigo
En la Estación Experimental de Sancti Spíritus de Cuba se realizó un experimento en invernadero para evaluar en trigo el efecto de la inoculación con las rizobacterias Sinorhizobium meliloti, Azospirillum zeae y Azospirillum canadense, y con el hongo Trichoderma harzianum.
Potencialidades de las bacterias diazotróficas asociativas en control de plagas en el cultivo de arroz
El arroz (Oryza sativa L.) representa el alimento básico para más de la mitad de la población mundial, considerado el cultivo más importante del mundo por la extensión de la superficie que ocupa y la cantidad de personas que dependen de su cosecha.
Mitos y Verdades sobre la berenjena
Solanum melongena es una especie vegetal conocida popularmente en Cuba como berenjena. Es muy común en la dieta alimentaria, pero solo debe ser consumida cuando está cocida, porque contiene alcaloides termolábiles que son muy tóxicos.
Sistemas agroecológicos como indicadores biológicos de la calidad del suelo
El Instituto de Ecología y Sistemática, CITMA en Cuba evaluó el impacto de los métodos agroecológicos a través de la variación de la mesofauna del suelo, en una finca con manejo integrado ganadería-agricultura (en Cangrejeras, provincia Artemisa).
Richmeat, primera empresa mexicana autorizada en Cuba
La empresa mexicana Richmeat de México, S.A. de C.V., dedicada al procesamiento y empacado de carne, se convirtió en la primera autorizada por Cuba para invertir en la llamada zona especial de desarrollo de Mariel, municipio de la Provincia de Artemisa.
Acuerdan instalar en Uruguay planta de leche en polvo con destino exclusivo a Cuba
El presidente Raúl Castro ofreció instalar en Uruguay una planta de leche en polvo, que tenga como destino exclusivo el mercado del país caribeño. Asi informo el Observador de Uruguay.
Nuevo programa de prevención de bacterias patógenas de larvas de Bombyx mori L
La sericultura constituye el único campo de la agricultura que se dedica a la reproducción a gran escala del gusano de seda (Bombyx mori L.), lepidóptero con alto valor económico y domesticado para la producción de seda por más de 5000 años.
Inversión pública para impulsar el cultivo de frutas y hortalizas en Cuba
Cuba invertirá unos US$100 millones para impulsar en el próximo quinquenio un programa que fomenta el cultivo de hortalizas y frutas en fincas y patios de la isla, anunció el ministro de Agricultura, Gustavo Rodríguez.
La biotecnología Cubana está entre los principales productos exportables
Representantes del Consejo Nacional de Investigaciones Científicas y Técnicas (CONICET) de Argentina y el Centro de Ingeniería Genética y Biotecnología (CIGB), acordaron que el laboratorio llevará el nombre del guerrillero argentino-cubano Ernesto Che Guevara.
La causa del envenenamiento de la toxina hipoglicina del Ackee o Palo de Seso
Existe una fruta en las islas del Caribe y gran parte de Latinoamérica llamada ackee (Blighia sapida) tan importante culturalmente que es considerada la fruta nacional en Jamaica, llegando incluso a estar representada en su bandera.